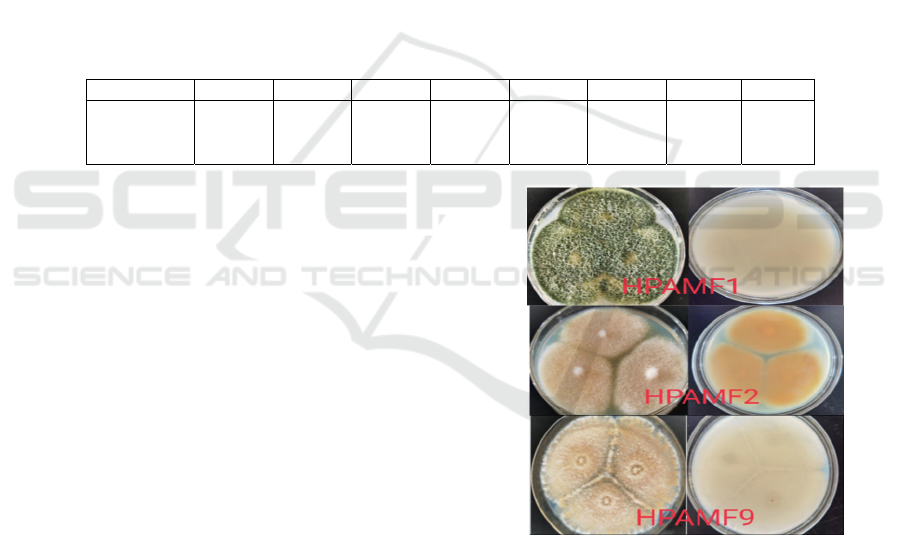

Screening and Characterization of Polyacrylamide Degrading Fungi
Yujie Cao
1
, Qingfang Zhang
1
, Minmin Zhao
1
, Chengxiang Bai
1
and Tianfeng Wang
1,2,*
1
School of Petrochemical Engineering, Lanzhou University of Technology, Lanzhou, Gansu, China
2
College of Resources and Environment, Jiujiang University, Jiujiang, Jiangxi, China
Keywords: Polyacrylamide, Degrading Fungi, Growth Characteristics, Degradation Conditions.
Abstract: In the study, soil samples around the oil concentration station of Yanchang Oilfield were selected for the
experiment. With 10
-2
as the soil dilution, the strains were screened by the plate stress enrichment culture
method. Finally, three strains of high polyacrylamide degrading fungi were determined, which were
respectively recorded as HPAMF1, HPAMF2 and HPAMF9. The rDNA-ITS assay showed that strains
HPAMF1, HPAMF2 and HPAMF9 were Trichoderma alba, Fusarium and Merimbla, respectively. The
growth characteristics and degradation conditions of the polyacrylamide degrading fungi were investigated
and optimized. It was found that the degradation capacity of the three strains reached the strongest when the
polyacrylamide was used as the sole nitrogen source.
1 INTRODUCTION
Polyacrylamide has flocculation
(Haveroen, 2005);
(Owen, 2002), adsorption
(Szögi, 2007); (Sojka,
2006), thickening, resistance reduction and other
properties, which has been widely used in petroleum
exploitation, water treatment, papermaking, textile
printing and dyeing, agriculture, medicine, sugar,
building materials, aquaculture, construction and
other fields (Shu, 2021); (Panova, 2021); (Yang,
2020).
Polyacrylamide is non-toxic, but it will undergo
physical, chemical, and biological degradation in
natural environment, and monomer acrylamide will
be produced after degradation. Acrylamide may
cause neurotoxicity, reproductive toxicity,
genotoxicity and carcinogenicity
(Huang, 2018).
Therefore, the degradation of polyacrylamide
wastewater has become a focus of attention in recent
years.
Biodegradation technology is low cost, non-
polluting and mature, which could be used in the
degradation of polyacrylamide
(Wijngaarden, 2016).
In the exploration of polyacrylamide degrading
microorganism, the study of bacteria is much more
than that of fungi. Because the species of known
polyacrylamide degrading fungus are few and the
research is not in-depth, this will become a new
direction of microbial polyacrylamide degrading.
2 MATERIAL AND METHODS
2.1 Sampling
The soil samples were taken from the surrounding
soil samples of an oil selection station in Yanchang
Oilfield.
Polyacrylamide purchased from Xi'an Lanxiang
Chemical Co., LTD., which is anion polyacrylamide,
with molecular weight of 5×10
8
.
2.2 Medium
2.2.1 Martin Medium
KH
2
PO
4
·3H
2
O 1 g, MgSO
4
·7H
2
O 0.5 g, peptone 5 g,
glucose 10 g, constant volume to 1000 mL. Prepare
rose-bengal with a concentration of 1% (m/m), and
add 3.3 mL to the culture solution. Stir thoroughly
until the mixture is evenly mixed, then weigh 15~20
g agar in the culture medium and heat to melt at
natural pH.
2.2.2 Basal Culture Medium
Sucrose 30 g, KH
2
PO
4
·3H
2
O 0.4 g, K
2
HPO
4
·3H
2
O
1.6 g, MgSO
4
·7H
2
O 0.06 g, NaCl 0.5 g, Fe
2
(SO
4
)
3
0.03 g, CaCl
2
0.01 g, CuSO
4
0.05 g, ZnSO
4
0.05 g,
with distilled water to 1000 mL at natural pH.
1296
Cao, Y., Zhang, Q., Zhao, M., Bai, C. and Wang, T.
Screening and Characterization of Polyacrylamide Degrading Fungi.
DOI: 10.5220/0011508800003443
In Proceedings of the 4th International Conference on Biomedical Engineering and Bioinformatics (ICBEB 2022), pages 1296-1301
ISBN: 978-989-758-595-1
Copyright
c
2022 by SCITEPRESS – Science and Technology Publications, Lda. All rights reserved

2.3 Screening of Degrading Fungi
2.3.1 Selection of Soil Dilution
Soil samples around the oil concentration station of
Yanchang Oilfield were taken and stored at 4 ℃. 2.0
g of soil sample was weighed and put into a conical
flask, which was placed in a constant temperature gas
bath oscillator at 34 ℃ and 140 rpm for 3 h. Then
dilute the soil suspension to 10
-1
, 10
-2
, 10
-3
, 10
-4
, and
10
-5
, and spread them evenly on Martin medium.
Make three parallel samples for each dilution. The
test was repeated three times for each strain. Observe
the growth of the colony in the culture medium and
select the appropriate soil dilution for subsequent
experiments.
2.3.2 Isolation of Polyacrylamide-degrading
Fungi
A certain amount of polyacrylamide was prepared
and added to the sterilized Martin culture medium by
means of plate stress enrichment method, where the
concentration of polyacrylamide was 100, 200, 500,
1000 and 1500 mg·L
-1
. A drop was added to Martin
medium containing polyacrylamide and coated
evenly. Three parallel samples were made for each
concentration and incubated at 34 ℃ for 72 h. fungi
with good growth and fast growth rate were selected
and further enriched and separated on Martin medium
containing polyacrylamide until pure colonies were
obtained.
2.3.3 Screening of Polyacrylamide
Degrading Fungi
The spores on each fungal body were washed with
phosphate buffer solution, and the spore suspension
was diluted to 10
6
CFU· mL
-1
, and stored in the
refrigerator at 4℃ for future use. The polyacrylamide
was added to the basal culture medium at a
concentration of 500 mg·L
-1
, and the spore
suspension were added to the medium at a volume
ratio of 2%. Then the suspensions were cultured in a
shaking table at 34 ℃ and 140 rpm for 10 days, and
the uninoculated solution was used as the control.
After the culture medium was diluted to an
appropriate concentration after being treated by each
fungus for 10 days, the absorbance was measured by
starch-cadmium iodide spectrophotometry, and the
change of polyacrylamide concentration was
obtained, and the degradation rate was calculated, so
as to screen out the polyacrylamide efficient
degradation fungi.
2.4 Identification of Efficient
Degradation Strains
1µL spore suspension was added to Martin medium,
and each fungus was repeated for three times. After
uniform coating, the bacteria were cultured in 34 ℃
incubator for 5 days, and the characteristics of each
colony were observed. The morphology of fungus
was observed by scanning electron microscope. The
strains were identified by rDNA-ITS assay.
2.5 Method for Determination of
Degradability of Each Fungus
Strains
The growth of polyacrylamide degraded fungus was
determined by dry cell weight. The polyacrylamide
concentration was determined by starch-cadmium
iodide method, and its removal rate was calculated.
2.6 Growth and Degradation
Characteristics of Single Each
Fungus
2.6.1 Growth with Polyacrylamide as the
Only Carbon Source
Three basal culture medium was prepared to remove
sucrose and added 500 mg·L
-1
NH
4
Cl, and then
inoculated with the three dominant strains which can
degrade polyacrylamide, respectively. Then the three
dominant strains were cultured at 34 ℃ in constant
temperature incubator, and the growth of the
degrading fungus was observed to explore whether
the three dominant strains could grow with
polyacrylamide as the only carbon source.
2.6.2 Growth with Polyacrylamide as the
Only Carbon and Nitrogen Source
Prepare three 500 mg·L
-1
basal culture medium with
polyacrylamide as the only carbon and nitrogen
source, and the three dominant fungi which can
degrade polyacrylamide isolated to basal culture
medium respectively, and then arrange them in a 34
℃ constant temperature incubator for culture, and
observe the growth of the degrading fungi. To explore
whether polyacrylamide can be used as the only
carbon and nitrogen source for the growth of the three
dominant strains.
Screening and Characterization of Polyacrylamide Degrading Fungi
1297
2.6.3 Single Growth Curve and
Polyacrylamide Degradation Rate
Curve
Three 500 mg·L
-1
basal culture medium containing
polyacrylamide were prepared and 2% (v/v)
sporospora suspensions of the three strains were
added, respectively. Three parallel groups were set in
each group, and they were placed in a 34 ℃ 140 rpm
shaking table for 10 days. The growth amount of the
fungi and the degradation rate of polyacrylamide
were measured every day.
3 RESULTS
3.1
Screening of Polyacrylamide
Degrading Fungi
After incubating in a constant temperature incubator
for 72 h, the plate with soil dilution of 10
-2
had more
types of colonies and was suitable for separation.
Different fungus was selected from the plate and
inoculated in Martin medium containing different
concentrations of polyacrylamide for stress
enrichment culture. The polyacrylamide
concentration was 100 mg·L
-1
, 200 mg·L
-1
, 500
mg·L
-1
, 1000 mg·L
-1
, 1500 mg·L
-1
. The growth of the
strains was observed in the incubator at 34 ℃ for 72
h, and the growing strains were selected for isolation
and purification. Finally, 8 strains of different
tolerance fungi were obtained.
In the basal medium containing 500 mg·L
-1
polyacrylamide, the suspensions of each sporozoa
were added at 2% (v/v). After 10 days of shaking
culture at 34 ℃ and 140 rpm, the absorbance was
measured to determine the concentration of
polyacrylamide, so as to obtain the degradation rate
of polyacrylamide by each fungus.
Table 1: Degradation ability of eight tolerant fungi to polyacrylamide.
Strains 1# 2# 3# 5# 6# 9# 10# 11#
Degradatio
n efficiency
(
%
)
27.36 27.99 14.75 18.30 22.76 27.58 9.51 23.77
As can be seen from Table 1, the degradation rate
of polyacrylamide of each degradation fungus were
different after 10 days, and 1#, 2# and 9# with higher
degradation rate than other strains were selected as
the dominant degradation fungus, which were
denoted as HPAMF1, HPAMF2 and HPAMF9.
3.2
Morphological Observation and
Identification of Polyacrylamide
Degrading Fungi
3.2.1 Colony Characteristics of
Polyacrylamide Degrading Fungi
The colony morphology was observed, and the
colony morphology was shown in Fig. 1. Observation
showed that HPAMF1 mycelia grew rapidly on the
medium, and the surface color of the colony changed
from white to yellowish green and then to dark green.
The HPAMF2 colony was grapefruit red, with
abundant velour shaped aerial mycelia, and the
mycelia were white, while the mycelia of HPAMF9
colony was light yellow, and the surface was nearly
smooth.
Figure 1: Cultural characteristic of HPAMF1, HPAMF2
and HPAMF9.
3.2.2 Characteristics of
Polyacrylamide-degraded Fungi
Three strains of fungi were placed under scanning
electron microscopy for observation, and the
scanning electron microscopy results of each strain
were shown in Fig. 2.
ICBEB 2022 - The International Conference on Biomedical Engineering and Bioinformatics
1298

Figure 2 SEM image of HPAMF1, HPAMF2 and
HPAMF9(×5000).
Under the scanning electron microscope, the
strain HPAMF1 was oblate with depressions; the
strain HPAMF2 was rod-shaped; and the strain
HPAMF9 was ellipsoidal with fine wrinkles on the
surface.
3.2.3 rDNA-ITS Determination
Through BLAST comparison, it is found that the
similarity between HPAMF1 and Trichoderma aspen
had reached 100%, the similarity between HPAMF2
and Fusarium sequence had reached 99.82%, and the
similarity between HPAMF3 and Merimbla sequence
had reached 99.48%. Therefore, HPAMF1 was
preliminarily identified as Trichoderma aspen,
HPAMF2 was preliminarily identified as Fusarium,
and HPAMF9 was preliminarily identified as
Merimbla through the determination of the colony
morphology, cell morphology and rDNA-ITS of
polyacrylamide-degrading fungi.
3.3
Growth and Degradation
Characteristics of Single Fungus
3.3.1 Growth of Degrading Fungi using
Polyacrylamide as the Sole Carbon
Source
HPAMF1, HPAMF2 and HPAMF9 were cultured in
a constant temperature incubator at 34 °C for 5 days.
It could be seen from Fig. 3 that HPAMF1 and
HPAMF9 have hyphae growth but HPAMF2 didn’t
grow. From this we could conclude that HPAMF1
and HPAMF9 grow with polyacrylamide as the sole
carbon source, but HPAMF2 didn’t.
Figure 3: HPAMF1, HPAMF2 and HPAMF9 grew with
polyacrylamide as the only carbon source.
Prepare basal culture medium with different
initial concentrations of polyacrylamide, in which
sucrose is removed and NH
4
Cl was added, and then
connected to the HPAMF1 and HPAMF9 spore
fungus suspension respectively, and placed in a
shaker at 34 ℃ 140 rpm for 10 days. After the
measurement, the degradation rate of polyacrylamide
is shown in Fig. 4.
Figure 4: Degradation curve of HPAMF1 and HPAMF9.
It can be seen from Fig. 4 that within the range of
the initial polyacrylamide concentration of 100~500
mg·L
-1
, the degradation rate of HPAMF1 and
HPAMF9 on polyacrylamide will increase rapidly as
the concentration increases, and both are at a
concentration of the maximum value is reached at
500 mg·L
-1
: 19.16%, 20.91%. When it exceeds 500
mg·L
-1
, with the continuous increase of the
concentration, the degradation rate presents an
obvious decreasing trend.
3.3.2 Growth of Degrading Fungi using
Polyacrylamide as the Only Carbon
and Nitrogen Source
Strains HPAMF1, HPAMF2 and HPAMF9 were
placed in a 34 ℃ constant temperature incubator for
5 days, and the experimental results were shown in
Fig. 5. It was observed that HPAMF1 and HPAMF9
could grow with polyacrylamide as the only carbon
and nitrogen source, while HPAMF2 could not.
0 500 1000 1500 2000 2500
0
5
10
15
20
25
HPAM
remova
l
e
ffi
c
i
ency
(%)
Initial concentration of HPAM (mg·L
-1
)
HPAMF1
HPAMF9
Screening and Characterization of Polyacrylamide Degrading Fungi
1299

Figure 5: HPAMF1, HPAMF2 and HPAMF9 grow with
polyacrylamide as the only carbon and nitrogen source.
In the basic culture medium with different initial
concentrations of polyacrylamide and sucrose
removed, two spore suspensions, HPAMF1 and
HPAMF9, were added, respectively, and placed in a
shaking table at 34
℃ and 140 rpm for culture for 10
days. During the experiment, the degradation rate of
polyacrylamide changed as shown in Fig. 6.
Figure 6: Degradation curve of HPAMF1 and HPAMF9.
As can be seen from Fig. 6, when the initial
concentration of polyacrylamide is in the range of
100~500 mg·L
-1
, the degradation rate of HPAMF1
and HPAMF9 on polyacrylamide will increase with
the increase of the concentration, and the degradation
rate of HPAMF1 will increase rapidly in the range of
100 mg·L
-1
to 200 mg·L
-1
. The degradation rate of
HPAMF9 increased rapidly from 200 mg·L
-1
to 500
mg·L
-1
, and both strains reached the maximum
degradation rate of 8.36% and 13.21% at 500mg·L
-1
.
When the initial concentration of polyacrylamide is
greater than 500 mg·L
-1
, the degradation rate
decreases with the increasing of the concentration.
3.3.3 Based on the above Experimental
Results
The degradation rates of HPAMF1 and HPAMF9
strains were 27.36% and 27.58%, respectively, when
the initial concentration of polyacrylamide was 500
mg·L
-1
as the only nitrogen source. When
polyacrylamide was used as the only carbon source,
the corresponding degradation rates were 19.16% and
20.91%, respectively. When polyacrylamide was
used as the only carbon and nitrogen source, the
corresponding degradation rates were 8.36% and
13.21%, respectively.
It was found that polyacrylamide was the only
nitrogen source for HPAMF2 growth. For HPAMF1
and HPAMF9 strains, polyacrylamide can be used as
the only nitrogen source, the only carbon source and
the only carbon and nitrogen source. According to the
data analysis, the degradation capacity of these three
strains can reach the strongest when they grow with
polyacrylamide as the only nitrogen source.
Therefore, in the subsequent experiments,
polyacrylamide was set as the only nitrogen source to
study the growth and degradation characteristics of
HPAMF1, HPAMF2 and HPAMF9.
3.3.4 Growth Curve and Degradation Rate
Curve of Single Fungus
Three strains of HPAMF1, HPAMF2 and HPAMF9
were cultured. The changes of thallus growth and
polyacrylamide degradation rate are shown in Fig. 7
and Fig. 8.
0246810
40
60
80
100
120
140
160
Biomass (mg)
Time (d)
HPAMF1
HPAMF2
HPAMF9
Figure 7: Growth curve of HPAMF1, HPAMF2 and
HPAMF9.
0246810
0
5
10
15
20
25
30
35
HPAM removal efficiency (%)
Time (d)
HPAMF1
HPAMF2
HPAMF9
Figure 8: Degradation rate curves of HPAMF1, HPAMF2
and HPAMF9.
0 500 1000 1500 2000 2500
2
4
6
8
10
12
14
16
HPAM removal efficiency (%)
Initial concentration of HPAM (mg·L
-1
)
HPAMF1
HPAMF9
ICBEB 2022 - The International Conference on Biomedical Engineering and Bioinformatics
1300

As shown in the Fig. 8, the growth curve of single
fungus HPAMF1, HPAMF2 and HPAMF9 was s-
type, in line with the microbial growth law. The strain
first passed a relatively short retardation period and
continuously adjusted itself to adapt to the new
environment. Then it entered the logarithmic growth
period, the fungus weight will show exponential
growth, at this time the degradation rate of
polyacrylamide will also increase; Then the strain
continued to grow into a stable phase, at which the
number of new cells and the number of dead cells
were in a dynamic balance, and the polyacrylamide
degradation rate tended to be stable. The maximum
removal rates of HPAMF1, HPAMF2 and HPAMF9
were 27.36%, 27.99% and 27.58%, respectively.
4 CONCLUSION
8 strains of polyacrylamide degrading fungi were
isolated from soil in this experiment. Moreover, the
dominant degradation fungi were selected through
the degradation effect of each strain on polyamide,
which were respectively recorded as HPAMF1,
HPAMF2 and HPAMF9. By observing the colony
morphology and cell characteristics of the three
fungus and identifying the three fungi, it was finally
concluded that strains HPAMF1, HPAMF2 and
HPAMF9 were Trichoderma alba, Fusarium and
Merimbla, respectively. In addition, in the growth
environment with polyacrylamide as the only
nitrogen source, the degradation ability of the three
fungi growth showed the strongest.
REFERENCES
Haveroen M E, MacKinnon M D, Fedorak P M.
Polyacrylamide added as a nitrogen source stimulates
methanogenesis in consortia from various wastewaters
[J]. Water research (Oxford), 2005, 39(14):3333-3341.
M Huang, J Jiao, J Wang, Z Xia, et al. Characterization of
acrylamide-induced oxidative stress and cardiovascular
toxicity in zebrafish embryos [J]. Journal of Hazardous
Materials,2018,347:451-460.
Owen A T, Fawell P D, Swift J D, et al. The impact of
polyacrylamide flocculant solution age on flocculation
performance[J]. International journal of mineral
processing, 2002,67(1):123-144.
Panova I G, Ilyasov L O, Khaidapova D D, et al. Soil
conditioners based on anionic polymer and anionic
micro-sized hydrogel: A comparative study[J]. Colloids
and Surfaces A: Physicochemical and Engineering
Aspects, 2021, 610: 125635.
Szögi A A, Leib B G, Redulla C A, et al. Erosion control
practices integrated with polyacrylamide for nutrient
reduction in rill irrigation runoff[J]. Agricultural water
management, 2007,91(1):43-50.
Sojka R E, Entry J A, Fuhrmann J J. The influence of high
application rates of polyacrylamide on microbial
metabolic potential in an agricultural soil[J]. Applied
soil ecology: a section of Agriculture, ecosystems &
environment, 2006,32(2):243-252.
Shu G, Bu K, Zhao B, et al. Evaluation of newly developed
reverse demulsifiers and cationic polyacrylamide
flocculants for efficient treatment of oily produced
water[J]. Colloids and Surfaces A: Physicochemical
and Engineering Aspects, 2021, 610: 125646.
van Wijngaarden L. Mechanics of collapsing cavitation
bubbles[J]. Ultrasonics sonochemistry, 2016, 29: 524-
527.
Yang K, Chen J, Liang S, et al. Preparation of super high
concentration cationic polyacrylamide emulsion and its
flocculation with cationic polymers[J]. Polymers for
advanced technologies, 2020,31(11):2711-2721.
Screening and Characterization of Polyacrylamide Degrading Fungi
1301
